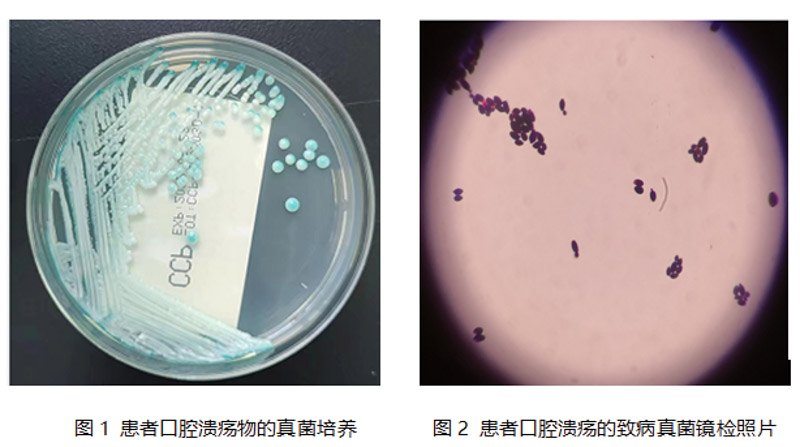

探秘柳州市人民醫院HIV抗體確證實驗室
醫學檢驗科就像是臨床醫生的“眼睛”,檢驗結果的及時性及準確性對于臨床診療有著舉足輕重的作用。柳州市人民醫院是柳州市為數不多擁有艾滋病確證實驗室的醫療單位。只有及時發現、診斷和治療人類免疫缺陷病毒感染,才能減少艾滋病傳播及改善病人預后。做好人類免疫缺陷病毒感染檢測工作對我國艾滋病防治具有非常重要的意義。醫學檢驗科各專業組加強溝通,聯合檢測,讓艾滋病診療更有效,讓患者更放心。
患者,女性,44歲,因口腔嚴重潰瘍反復發作來我院就醫。口腔科醫生認真細致查看了患者口腔情況,不由地倒抽一口涼氣,只見數個拇指大小的灰白色潰瘍布滿了患者口腔,醫師立即從潰瘍面上取下少量白色組織送檢。醫學檢驗科微生物實驗室的“偵探們”在顯微鏡下找到了口腔潰瘍的兇手-白色念珠菌!(如圖1、圖2所示)
明確為真菌感染后,抗真菌治療一個月,然而真菌感染情況并沒有得到有效控制,潰瘍情況好了又壞,看來真菌感染只是幫兇,真正兇手是讓患者的免疫功能缺失,才讓真菌們有機可乘。經過進一步的檢驗,真兇的蛛絲馬跡才顯露出來,患者CD4+淋巴細胞明顯減少,CD4+/CD8+T淋巴細胞倒置(如圖3所示),存在明顯的免疫功能缺陷,而患者的HIV抗體初檢結果為待確定(如圖4所示)。

到底是不是艾滋病呢?必須進行進一步的檢測:HIV抗體確證試驗。經過檢測,該患者HIV抗體所有特征蛋白均檢出,結論HIV抗體確證檢測陽性。根據《WS293-2019 :艾滋病和艾滋病病毒感染診斷標準》,結合患者臨床表現,最終確認為HIV感染。患者確診后,感染性疾病科可以根據醫學檢驗科分子生物學、HIV病毒載量、細胞免疫功能和結核桿菌感染的檢測結果,為不同時期的HIV感染患者制定個體化治療方案。
也許大家都會問,為什么HIV抗體初檢結果是“待確定”而不是陽性?什么是“HIV抗體確證試驗”?為什么“HIV抗體確證試驗”具有“一錘定音”的功效?艾滋病是一種危害性極大的傳染性疾病,由HIV病毒引起,它能攻擊人體的免疫系統,把人體免疫系統中最重要的CD4淋巴細胞作為主要攻擊目標,大量破壞該細胞,使人體喪失免疫功能,因此人體易于感染各種疾病,病死率較高。人體感染HIV病毒后,3-7天病毒迅速增殖,并刺激機體產生抗HIV抗體,抗HIV抗體對HIV病毒并沒有殺滅作用。HIV抗體是一組復雜的蛋白組分,在感染后5-30天內先后產生不同組分的HIV抗體。隨著檢測HIV抗體的試劑越來越靈敏,四代檢測試劑已經能檢測出感染后3天產生的蛋白組分,但由于靈敏度太高,不可避免容易檢測出假陽性的蛋白組分。

所以,HIV抗體初篩試驗呈現陽性反應時,我們并不能斷論就是HIV病毒感染,我們還需要更準確的“HIV抗體確證試驗”!顧名思義,確證試驗就是“確定、證實結論的試驗”。HIV抗體確證試驗能檢測出所有HIV抗體的不同組分,只有當所有的特異性蛋白組分被檢測出來,才能定論“HIV抗體陽性”,從而證實“感染HIV病毒”!

▲歐蒙免疫印跡儀(確證試驗)
HIV抗體確證試驗結果的重要性不言而喻。它能確證“感染HIV病毒”,也能排除感染HIV病毒,把患者從HIV感染的恐懼懸崖邊拉回來。在醫院沒建立HIV抗體確證實驗室以前,患者的樣本需要送到柳州市疾控中心進行確證試驗,報告至少需要等待半個月以上,而現在1周以內即可拿到HIV抗體確證報告。最終“HIV抗體陰性”的確證報告讓患者舒了一口氣。
HIV抗體確證試驗結果如此重要,國家即制定了嚴格的準入制度,以保障“HIV抗體確證試驗”的質量。開展“HIV抗體確證試驗”的實驗室必須經過長期的技術沉淀,具備萬無一失的質量管理體系和生物安全防范措施,技術人員必須具備5年以上HIV抗體初篩試驗專項工作經驗和省級專項培訓,經自治區專家組考核評審方可獲得相關資質。柳州市人民醫院醫學檢驗科是市級綜合醫院中第一家獲得相關資質的實驗室。
多種亞專業技術聯合用
為HIV感染者的健康保駕護航
柳州市人民醫院醫學檢驗科自2005年獲得HIV抗體篩查實驗室資質開展HIV抗體篩查試驗以來,歷經16年,無一例醫療差錯事件發生。2021年底通過考核評審,成為HIV抗體確證實驗室。

▲臨床免疫檢驗實驗室團隊
醫學檢驗科也在科內大力發展跨專業聯合診療,整合微生物實驗室、臨床免疫實驗室、分子生物學檢測實驗室3大亞專業學科檢驗技術,在HIV感染引起的艾滋病及其伴隨感染的診斷、治療、病情監測和預后等管理方面綜合運用以發揮更全面準確的作用,能為HIV感染患者的健康管理提供一站式服務。
圖、文:檢驗科 韋桂喜、劉綱毅
